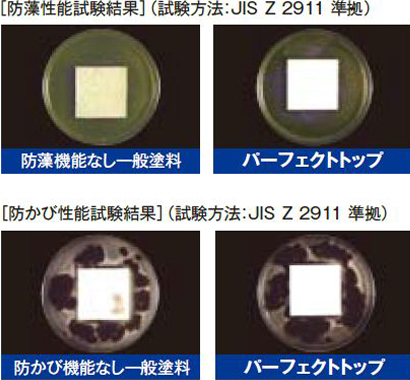

ハイブリッド塗料(日本ペイント パーフェクトトップ)のおすすめ4つのポイント



日本ペイントのパーフェクトトップは【1液水性ラジカル制御形ハイブリッド高耐候性塗料】とも言います。
特許申請中の「ラジカル制御」技術で塗膜の劣化を抑え、シリコンよりも優れた耐候性が可能になっています。
「ラジカル」とは、塗膜に紫外線があたると発生する顔料の主成分である酸化チタンから発生する分子で、樹脂同士の結合を破壊する性質をもっています。
このラジカル分子の発生を抑える事ができる技術を持っている事でグレードの高い塗料が誕生しました。
さらに、「ラジカル」を捕まえる機能をもつ、光安定剤の併用によりダブルの効果で耐候性を高める事ができています!
塗料の特長を星5つのグレードで表してみました。星の数が多いほど、優れているという事です。

![]()

 「ラジカル制御」技術によりシリコンよりも高い耐候性を実現!
「ラジカル制御」技術によりシリコンよりも高い耐候性を実現!
耐候性の実力は、JIS A 6909耐候形1種に該当します。促進耐候性試験で2,500時間経過後、光沢保持率が80%以上である塗料が該当します。
一般従来シリコン樹脂塗料塗料と一般従来フッ素樹脂塗料の中間に位置するグレードの塗料です。
 緻密でなめらかな塗膜形成が可能!優れた光沢を実現!
緻密でなめらかな塗膜形成が可能!優れた光沢を実現!
この緻密な塗膜形成ができる理由は、ポリマーが膜間の隙間が埋めてくれる為です。
美しい外観を保持する為には、つや感はとても重要です。つやを強くしたくない場合でも、落ち着きのある3分つや、つや消しなどの調整も可能です。
 いやな藻やカビの発生もしっかり抑制します!
いやな藻やカビの発生もしっかり抑制します!
低汚染性・防藻・防カビ機能を標準で有しています。
親水化技術により、低汚染性を発揮する事で、雨だれ汚染に対して優れた効果を発揮します。
 高い透湿性により、結露から建物を守ります!
高い透湿性により、結露から建物を守ります!
【神奈川県】
横浜市鶴見区, 横浜市神奈川区, 横浜市西区, 横浜市中区, 横浜市南区, 横浜市保土ヶ谷区, 横浜市磯子区, 横浜市金沢区, 横浜市港北区, 横浜市旭区, 横浜市戸塚区, 横浜市港南区, 横浜市緑区, 横浜市瀬谷区, 横浜市栄区, 横浜市泉区, 横浜市青葉区, 横浜市都筑区, 川崎市川崎区, 川崎市幸区, 川崎市中原区, 川崎市高津区, 川崎市多摩区, 川崎市宮前区, 川崎市麻生区, 相模原市緑区, 相模原市中央区, 相模原市南区
など
【東京都】
目黒区, 大田区, 世田谷区, 渋谷区, 中野区, 杉並区, 町田市
など
株式会社太陽電工
〒222-0033 神奈川県横浜市港北区新横浜3-7-18 日総第18ビル 6階
Copyright © 太陽電工 All Rights Reserved.